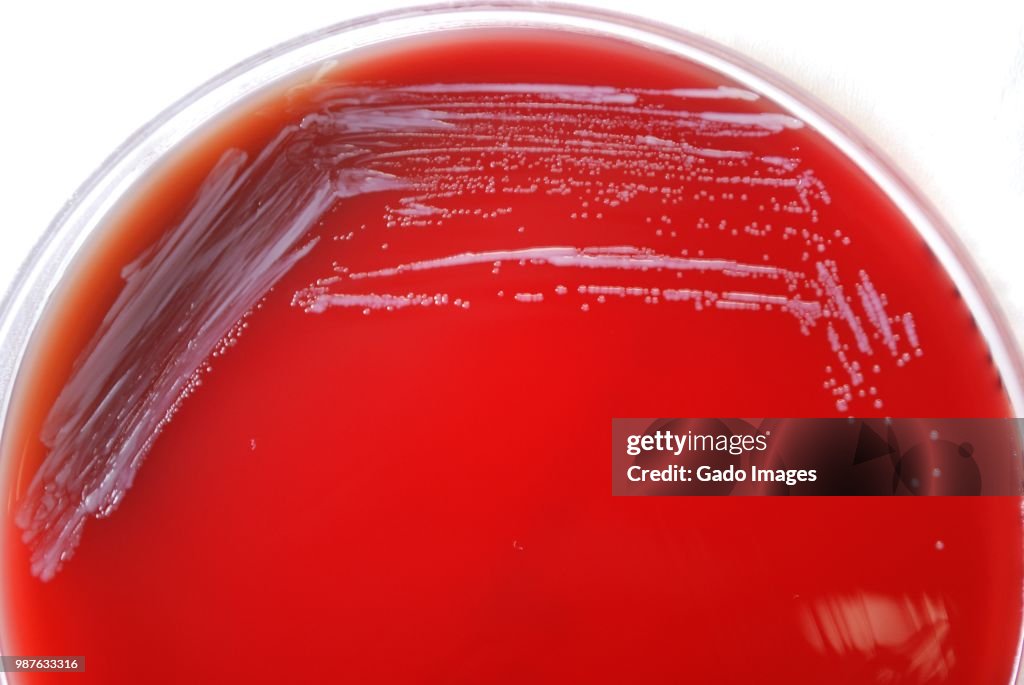
Brucella Abortus Bacteria

Brucella Abortus Bacteria - Stock-Fotografie
Colonial morphology of Gram-negative Brucella abortus bacteria grown 48 hours on a medium of sheep's blood agar (SBA), 2010. Image courtesy Centers for Disease Control (CDC) / Dr Todd Parker, Audra Marsh. (Photo by Smith Collection/Gado/Getty Images)

Sichern Sie sich dieses Bild in einem von vielen Rahmen auf Photos.com.
EINE LIZENZ KAUFEN
Alle Lizenzen für lizenzfreie Inhalte beinhalten weltweite Nutzungsrechte, umfangreichen Schutz und eine einfache Preisgestaltung mit Mengenrabatten
335,00 €
EUR
Getty ImagesBrucella Abortus Bacteria, Stock-Foto Laden Sie authentische Premium-Fotos zum Thema Brucella Abortus Bacteria von Getty Images herunter. Entdecken Sie ähnliche hochauflösende Fotos in unserem umfangreichen Bildkatalog.Product #:987633316
Laden Sie authentische Premium-Fotos zum Thema Brucella Abortus Bacteria von Getty Images herunter. Entdecken Sie ähnliche hochauflösende Fotos in unserem umfangreichen Bildkatalog.Product #:987633316
Laden Sie authentische Premium-Fotos zum Thema Brucella Abortus Bacteria von Getty Images herunter. Entdecken Sie ähnliche hochauflösende Fotos in unserem umfangreichen Bildkatalog.Product #:987633316
Laden Sie authentische Premium-Fotos zum Thema Brucella Abortus Bacteria von Getty Images herunter. Entdecken Sie ähnliche hochauflösende Fotos in unserem umfangreichen Bildkatalog.Product #:987633316335€50€
Getty Images
In stockDETAILS
Bildnachweis:
Creative #:
987633316
Lizenztyp:
Kollektion:
Photodisc
Max. Dateigröße:
5300 x 3547 px (44,87 x 30,03 cm) - 300 dpi - 4 MB
Hochgeladen am:
Ort:
United States
Releaseangaben:
Keine Freigaben erforderlich